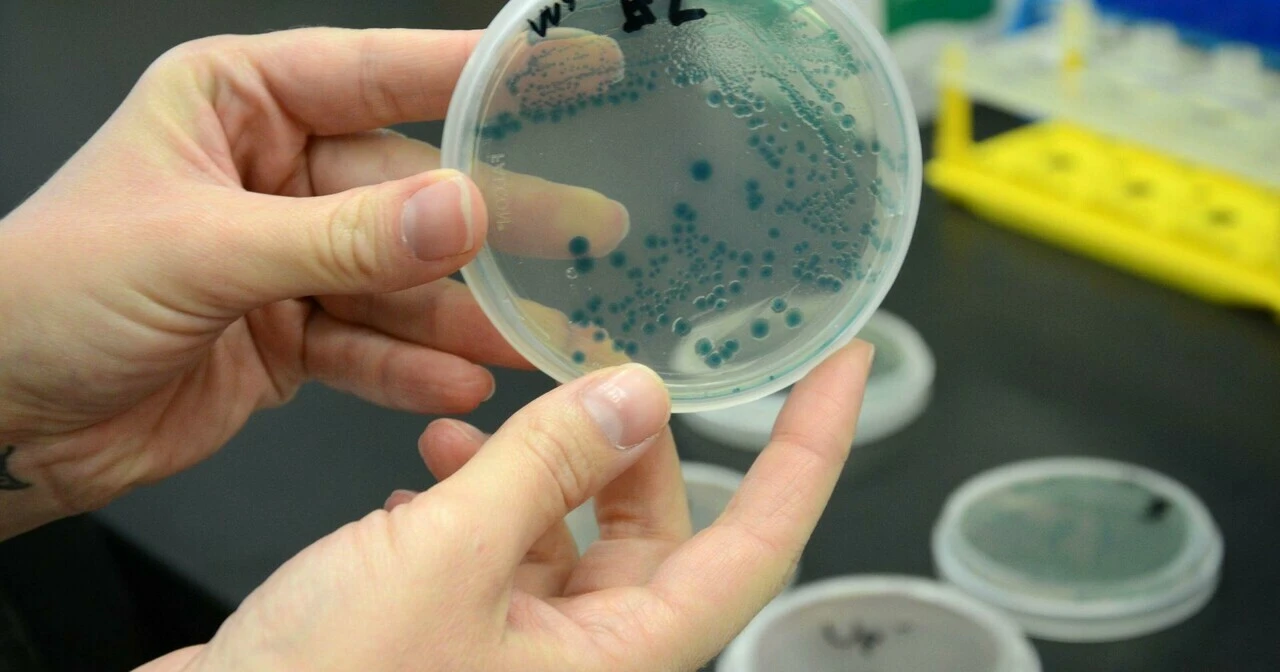
Et yiyen bakteri alarmı! Vakalar arttı insanlar uzuvlarını kaybedebiliyor

Kategoriler
UYGULAMALAR
İstanbul

Geçtiğimiz ay ABD'yi yerle bir eden Ian Kasırgası nedeniyle Florida eyaletinde, et yiyen bakteri hastalıkları (Vibrio vulnificus) ve ölüm vakalarındaki artış ile mücadele etmek daha da zorlaştı. Eyaletin Lee County şehrinde et yiyen bakteri nedeniyle enfekte olan 29 onaylanmış vaka ve 4 ölüm görüldü. 2021 yılında sadece 5 vaka ve 1 ölüm kaydedildi. 2020'de ise Lee County'de hiç vaka görülmemişti. Eyalet çapında ise et yiyen bakteri nedeniyle enfekte olan hastaların sayısı 2021'de 34 ve 2020'de 36'dan 2022'de 65'e yükseldi.
Lee County sağlık yetkilileri tarafından yapılan açıklamada, şu ifadelere yer verildi:
"Bir kasırganın ardından oluşan sel suları Vibrio vulnificus gibi bulaşıcı hastalıklar da dahil olmak üzere birçok risk oluşturuyor. Ian Kasırgası'nın neden olduğu gibi kıyı sularındaki kanalizasyon sızıntıları bakteri seviyelerini artırdı. Açık yaraları veya kesikleri olan kişiler, deniz suyuna doğrudan temas yoluyla Vibrio Vulnificus'a maruz kalabilirler.''
Et yiyen bakteri, genellikle ılık ve acı olan suda bulunuyor. ABD Hastalık Kontrol ve Önleme Merkezi'ne (CDC) göre, genellikle bir insanın vücuduna çiğ ya da az pişmiş istiridye ve kabuklu deniz ürünleri yediklerinde ulaşıyor. Bakteriler açık bir yaranın ılık deniz suyuna maruz kalması durumunda da cildi enfekte edebiliyor.

Vakaların en çok görüldüğü Lee County'nin Sağlık Departmanı, herhangi birinin enfekte olabilmesine rağmen bu enfeksiyonun bağışıklık sistemi zayıf olanlarda özellikle tehlikeli olabileceği konusunda uyardı. Kurum, “Vibrio vulnificus birinin kan dolaşımına girerse ateş, titreme, septik şok ve deride kabarcıklar gibi belirtilerle ölümcül hastalıklara neden olabilir” açıklamasını yaptı.
#haber#
Öte yandan et yiyen bakteri, açık bir yaranın etrafındaki eti yiyerek ciddi bir enfeksiyona neden oluyor. Hastalığın ilerlemesi durumunda ise insanların kol ve bacak gibi uzuvlarını kaybetmesine neden olabiliyor.
CDC, et yiyen bakteri enfeksiyonunun belirtileri arasında kırmızıya dönen yaralar, deride şişme, yüksek ateş, nefes darlığı, yüksek kalp hızı gibi semptomların yer aldığını açıkladı.